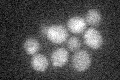
YGR049W
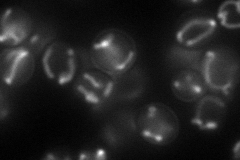
YGR049W
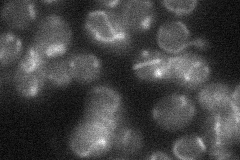
YGR049W

View description
Potential regulatory effector of CDC4 function, suppresses a temperature-sensitive allele of CDC4, tripartite protein structure in which a charged region separates two uncharged domains, not essential for mitosis or meiosis
Localization:
Intensity:
Fold change:
Significance:
-
C’ GFP library in SD
below threshold17.24 -
N' NOP1pr-GFP in SD
mitochondria66.2668 -
N' TEF2pr-mCherry in SD

mitochondria108.489 -
N' NATIVEpr-GFP in SD
mitochondria19.6115 -
N' TEF2pr-VC and Cyto-VN in SD

mitochondria28.9271 -
C’ GFP library in SD+DTT

cytosol14.960.86No -
C’ GFP library in SD+H2O2

cytosol16.270.94No -
C’ GFP library in Starvation Media

cytosol17.721.02No -
C’ GFP library on the background of Pup2-DaMP

below threshold -
C’ GFP library on the background of CCT mutant

below threshold16.31420.945936No
